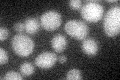
YNL243W
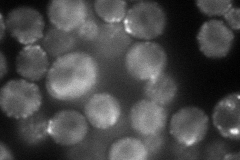
YNL243W
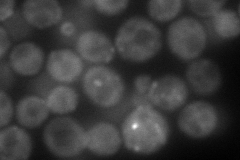
YNL243W
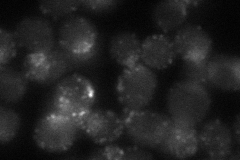
YNL243W
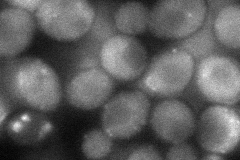
YNL243W
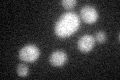
YNL243W
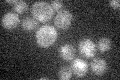
YNL243W

View description
Transmembrane actin-binding protein involved in membrane cytoskeleton assembly and cell polarization; adaptor protein that links actin to clathrin and endocytosis; present in the actin cortical patch of the emerging bud tip; dimer in vivo
Localization:
Intensity:
Fold change:
Significance:
-
C’ GFP library in SD
below threshold18.43 -
N' NOP1pr-GFP in SD
punctate,bud neck124.386 -
N' TEF2pr-mCherry in SD
punctate,bud neck139.806 -
N' NATIVEpr-GFP in SD
punctate,bud neck40.6093 -
N' TEF2pr-VC and Cyto-VN in SD
cytosol,bud neck57.3431 -
C’ GFP library in SD+DTT
cytosol14.650.79No -
C’ GFP library in SD+H2O2

cytosol16.250.88No -
C’ GFP library in Starvation Media
cytosol16.540.89No -
C’ GFP library on the background of Pup2-DaMP

below threshold -
C’ GFP library on the background of CCT mutant

below threshold15.5150.841266No
